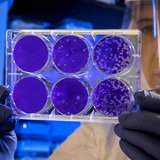

Sigurno ste kroz to prolazili, bar u nekom periodu života - treba da zaspite, ali prosto niste u stanju. I tako, taj vaš pokušaj traje, traje. Nekada do ponoći, nekada do duboko u noć, a nažalost, nisu retki ni slučajevi onih koji bi tako dočekivali jutarnji alarm za posao. 😬
Zapravo, zvanični podaci kažu da većina žitelja većih gradova ima neki problem sa spavanjem, dok oko trećine prosto nije u stanju da zaspi bar jedan dan u nedelji, što, kao što je poznato, ostavlja posledice i za svakodnevni život.

Foto: redportal.rs / AI
Nesanica, naravno, kao i lekova za istu - ima raznih vrsta, tako da ćete često naletati na savete da ne gledate ekrane do kasno u noć, a nije strana ni preporuka raznih suplemenata.
Ipak, naučnik po imenu Kajl Koks (inače aktivan na mrežama, pogotovo na Instagramu pod imenom @kyleinspires1), a čiji je cilj ponovno tumačenje trauma kroz nauku, ovih dana je podelio objavu u kojoj je objasnio novu metodu koju, kako kaže, specijalne klinike za lečenje nesanice sada koriste umesto tableta.
Naime, on je rekao da se dubok san može postići prostim stavljanjem nečeg hladnog na čelo. 😨😴 Naravno, iako ovo zvuči suviše jednostavno da bi bilo istinito, kada ga saslušate, videćete da to zapravo ima dosta smisla. 🤔👇
IZVOR: IG / @kyleinspires1
- Otkriveno je da temperatura vašeg čela kontroliše da li vaš mozak ostaje budan ili se gasi. Kada se vaš frontalni režanj ohladi čak i za 1 stepen, to automatski pokreće hemiju sna - objasnio je on.
U nastavku snimka Kajl je objasnio da je ova metoda testirana na ljudima sa nesanicom, gde su im date kape za hlađenje koje su dodirivale samo čelo, što je dovelo do toga da većina njih zaspi znatno brže nego nakon uzimanja tableta za spavanje.
Ono što je zanimljivo jeste da je studija koja ovo dokazuje predstavljena na jednoj konferenciji još 2011. godine, a utvrđeno je da je stopa uspeha ove metode iznosila preko 75%.
- Spoljna hladnoća usporava svo tu mentalno 'brbljanje', jer onda vaš prefrontalni korteks bukvalno ne može da se zagreje kada se hladi - objasnio je neuronaučnik.

Foto: Unsplash.com/@sammywilliams
A šta je najpraktičnije uraditi? Verovali ili ne - on je preporučio običnu krpu ili peškir. 😄
- Hladna krpa za pranje može da pomogne, ili čak kesica smrznutog graška umotana u tanki peškir. Njih prosto stavite na čelo kada legnetet, ostavite dok se ne zagreje i dok se vaše užurbane ne uspore. Tada promena temperature govori vašem mozgu da je noć, čak i ako još uvek ne možete da se otarasite razmišljanja o svačemu - rekao je on.
Kako to obično biva, javilo se dosta ljudi koji su sami primetili efikasnost ove metode, tako da su neki preporučivali hladne maske za oči i sl, dok su se neki setili i metode majki iz nordijskih zemalja, kojima je potpuno normalno da ostavljaju decu ispred kuće u kolicima, na hladnoći.
Bilo kako bilo, i mi preporučujemo i ovu metodu, jer svakako zima nailazi.

Autor: redportal.rs